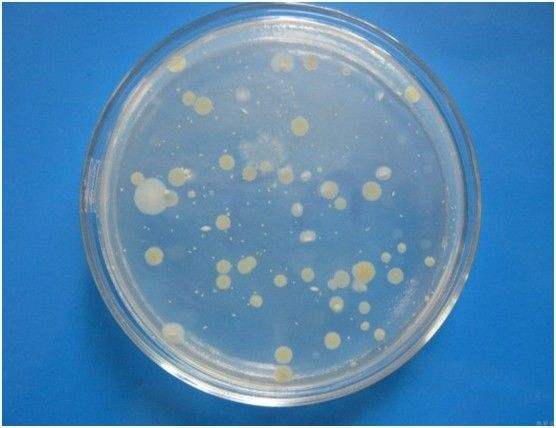

-
91抖音下载入口91抖音短视频中總餘氯同樣重要!
其實說到91抖音短视频大家多少會有些擔心,擔心這類廢水直接排除會帶來多大的傷害!做好91抖音短视频在線91抖音下载入口工作,確保水質達標排放才行!......【點擊詳情】
-
不要找理由忽略廢水的安全排放
廢水排放安不安全會直接對生態環境和人體健康帶來威脅,所以千萬不要找任何理由忽略了廢水的安全性。......【點擊詳情】
-
淺談提升水汙染監控力度問題
在人類生產活動中,往往會把大量的工業、農業和生活廢棄物排入水中,造成水資源的嚴重汙染。本文將91抖音免费版小編來淺談下提升水汙染監控力度問題。......【點擊詳情】
-
飲用水水質91抖音下载入口方法分類有哪些?
做好水質91抖音下载入口工作是保障飲用水安全的重要環節,因為隻有對水質進行分析91抖音下载入口後各項指標都達標了,才可以放心使用,不然會帶來嚴重後果。本文91抖音免费版一起來了解飲用水水質91抖音下载入口.........【點擊詳情】
-
用什麽方法來測量水中餘氯含量?
利用總餘氯在線分析儀來進行監控,保障氯的投放量。本文91抖音免费版來了解下用什麽方法測量水質的常見方法。......【點擊詳情】
-
常見汙水消毒的措施,如何控製餘量?
汙水處理過程中消毒也是很重要的環節,通過消毒劑來對汙水廢水中的有害進行消滅,從而保障水質質量問題。......【點擊詳情】
-
得知煤化工廢水的危害,讓你更相信廢水91抖音下载入口的重要性!
煤炭資源是我國的重要基礎資源,煤化工泛指煤的氣化,焦化加工等。得知煤化工廢水的危害,讓你更相信廢水91抖音下载入口的重要性!......【點擊詳情】
-
三種檢測大腸菌群方法的關係
檢測水中大腸菌群是評價水質質量的重要指標,如:91抖音短视频在線91抖音下载入口、飲用水91抖音下载入口等。......【點擊詳情】
-
菌落總數可用來衡量飲用水質量
菌落總數不僅是91抖音短视频在線91抖音下载入口的重要指標,同時在衡量飲用水質量也有菌落總數這個指標。......【點擊詳情】
-
水中重金屬汙染物(鎘)指標測定
水質重金屬汙染主要指的就是鉛、鋅、鎳、鉻、汞、鎘、銀等物質,做好廢水91抖音下载入口工作很關鍵,本文小編和大家一起了解關於水中重金屬汙染物(鎘)指標的測定問題。......【點擊詳情】
欄目導航
- 公司動態
- 行業91抖音APP下载
- 公司動態
聯係91抖音免费版
-
服務熱線0571-28993551
- 電話:13754313176
- 地址: 浙江省杭州市拱墅區康中路16號
網站首頁>91抖音APP下载中心 >公司動態